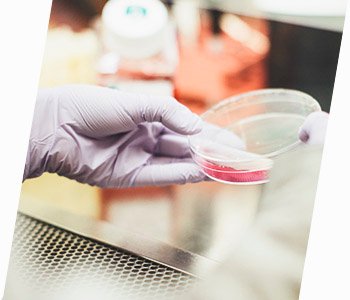

Мы встретились со специалистами центра вспомогательных репродуктивных технологий «АльтраВита» и узнали о возможных альтернативных способах лечения бесплодия, которые помогут тебе зачать ребенка.

Причины бесплодия довольно разнообразны. Ты можешь удивиться, но в 30-40% случаев встречается мужской фактор бесплодия, поэтому важно, чтобы обследование вы проходили вместе с партнером. Наиболее распространенными факторами, приводящими к бесплодию у мужчин, являются проблемы с качеством спермы, дефицит тестостерона, нарушение эякуляции, а также варикоцеле — расширение вен семенного канатика, которое приводит к нарушению образования сперматозоидов.
Женщины, как правило, сталкиваются с более широким спектром препятствий на пути к беременности. Одним из наиболее распространенных факторов бесплодия является трубно-перитонеальный — это нарушение проходимости маточных труб или их отсутствие вследствие различных оперативных вмешательств на органах малого таза. Далее следует бесплодие, связанное с отсутствием овуляции у женщин, которое может быть вызвано дисгормональными явлениями, синдромом поликистозных яичников, синдромом резистентных яичников. Также одним из распространенных факторов, препятствующих беременности, является различной распространенности эндометриоз.
Ниже представлены программы вспомогательных репродуктивных технологий, о которых стоит знать, если ты столкнулась с проблемой фертильности:
1. Стимуляция овуляции

Этот способ предполагает прием лекарственных препаратов для стимуляции функции яичников, что увеличивает вероятность зачатия посредством естественного полового акта или искусственной инсеминации.
Показания: гормональные дисфункции, синдром поликистозных яичников, подготовка к экстракорпоральному оплодотворению, длительный прием комбинированных оральных контрацептивов, который осложнился угнетением функции яичников, повышенное количество мужских половых гормонов в крови пациентки.
Противопоказания: Стимуляцию овуляции яичников не проводят в случаях выявленной внутриматочной патологии, острых воспалительных процессов в органах малого таза, непроходимости маточных труб, а также мужского бесплодия.
Какие обследования надо пройти: осмотр терапевта, ЭКГ, УЗИ малого таза и молочных желез. Исследование проходимости маточных труб методом лапароскопии или рентгенографии, или под ультразвуковым контролем, флюорографию, анализы крови и общий анализ мочи, исследование мазков из влагалища, цервикального канала и уретры на атипичные клетки и степень чистоты.
Суть метода: Наиболее простой метод — назначение гормональных таблеток для стимуляции овуляции. Если препарат неэффективен, могут потребоваться инъекции небольшой дозы гонадотропинов — гормональных препаратов, стимулирующих рост более одного фолликула в яичниках пациентки.
2. Инсеминация
Показания: В программе искусственной инсеминации может применяться сперма супруга или сперма донора. В первом случае используют сперму партнера женщины, во втором — сперму анонимного донора из банка спермы. Гомологичное осеменение можно использовать в случае, если в эякуляте слишком мало спермы или сперматозоиды недостаточно подвижны, а также при бесплодии цервикального происхождения. Искусственную инсеминацию спермой донора стоит рассмотреть, если партнер женщины бесплоден или у него тяжелое наследственное заболевание, а также при выявлении у пары несовместимости при зачатии.
Противопоказания: тяжелые психические заболевания, выраженная патология матки, опухоли яичников, онкологические и воспалительные процессы.
Какие обследования надо пройти: пациентке необходимо сдать анализы крови, мазков на флору, онкоцитологию и половые инфекции, биохимический анализ крови и коагулограмму, УЗИ щитовидной железы и молочных желёз, ЭКГ, эхокардиографию, флюорографию, а также пройти консультации у врача маммолога, врача эндокринолога и врача терапевта.
Суть метода: Инсеминация предполагает введение здоровой концентрированной, предварительно подготовленной андрологами спермы супруга или донора в полость матки матери незадолго до или в день овуляции. Это сокращает время и расстояние путешествия сперматозоида до яйцеклетки, что облегчает процесс оплодотворения. Момент овуляции определяется врачом при использовании ультразвукового сканирования и анализа крови на уровень гормонов. Врач вводит ее в полость матки с помощью мягкого катетера. Так сперматозоиды гораздо быстрее достигают цели и встречаются с яйцеклеткой.
3. Экстракорпоральное оплодотворение

Экстракорпоральное оплодотворение (ЭКО) это высокотехнологичная программа преодоления бесплодия. Метод считается одним из самых эффективных способов лечения отсутствия беременности в паре во всем мире: частота наступления беременности с помощью ЭКО в среднем составляет 47%. Обычно в организме женщины формируется одна яйцеклетка за весь период менструального цикла, но программа ЭКО направлена на рост и развитие максимального количества фолликулов в яичниках с целью получения наибольшего количества яйцеклеток хорошего качества, которые затем оплодотворяют.
Показания: у женщин это — патология маточных труб и их отсутствие вследствие оперативных вмешательств на органах малого таза, ановуляторный менструальный цикл, тяжелые формы наружного генитального эндометриоза, синдром поликистозных яичников, у мужчин — патология спермы, органическая патология мужской репродуктивной функции, дисгормональные явления, а также генетический фактора бесплодия.
Противопоказания: категорически запрещено проводить ЭКО при наличии таких заболеваний, как легочная гипертензия, апластическая анемия, гиперпаратиреоз, злокачественные опухоли.
Какие обследования надо пройти: перед процедурой врачи рекомендуют будущим родителям проверить состояние здоровья, в частности УЗИ малого таза, УЗИ щитовидной железы, УЗИ молочных желез, клинико-лабораторное обследование супружеской пары, которое включает в себя множество анализов, в том числе анализы крови на ВИЧ, сифилис, гепатиты В и С.
Суть процедуры: Во время ЭКО яйцеклетки извлекаются из фолликулов с помощью специальной трансвагинальной пункционной иглы и оплодотворяются в лабораторных условиях. Процедура может быть выполнена с использованием собственных яйцеклеток и спермы партнера или донора. Далее полученные эмбрионы для дальнейшего роста и развития помещают в инкубатор с питательной средой и оставляют там на несколько дней. Затем эмбрион переносят в полость матки пациентке. Эффективность программы ЭКО, ее исход, то есть долгожданная беременность определяется с помощью анализа крови на концентрацию хорионического гонадотропина человека. Обычно анализы проводятся спустя 14 дней после переноса эмбриона в полость матки. Даже при положительных результатах не стоит забывать, что в первом триместре беременности риски невынашивания достаточно высоки, по этой причине важно следить за самочувствием и состоять на учете по беременности у врача акушера-гинеколога.
4. Подсадка размороженных эмбрионов

5. Суррогатное материнство

Суррогатное материнство – метод зачатия, требующий участия трех сторон: предполагаемых родителей и суррогатной матери, которая согласна добровольно или за оговоренную сумму выносить и родить ребенка для супружеской пары. Суррогатной матерью может стать любая женщина в возрасте от 20 до 34 лет, физически и психически здоровая, при наличии собственного здорового ребенка.
Показания: Обычно женщины прибегают к методу суррогатного материнства по следующим причинам: выраженная патология эндометрия, врожденная патология матки или отсутствие матки, вследствие гистерэктомии, в случае, когда беременность связана с риском для жизни женщины, а также при многократных неудачных ЭКО или частых выкидышах.
Какие обследования надо пройти: претендент на участие в программе суррогатного материнства должна пройти ряд исследований, подтверждающих отличное состояние ее здоровья, в частности осмотр и консультация акушера-гинеколога, анализы крови, коагулограмму, общий анализ мочи, мазок из цервикального канала и уретры, цитологическое исследование соскоба с шейки матки, УЗИ молочных желез и органов малого таза, электрокардиограмма и флюорографию.
Суть метода: перенос эмбриона, принадлежащий пациентам, в полость матки суррогатной матери в цикле заместительной гормональной терапии.















